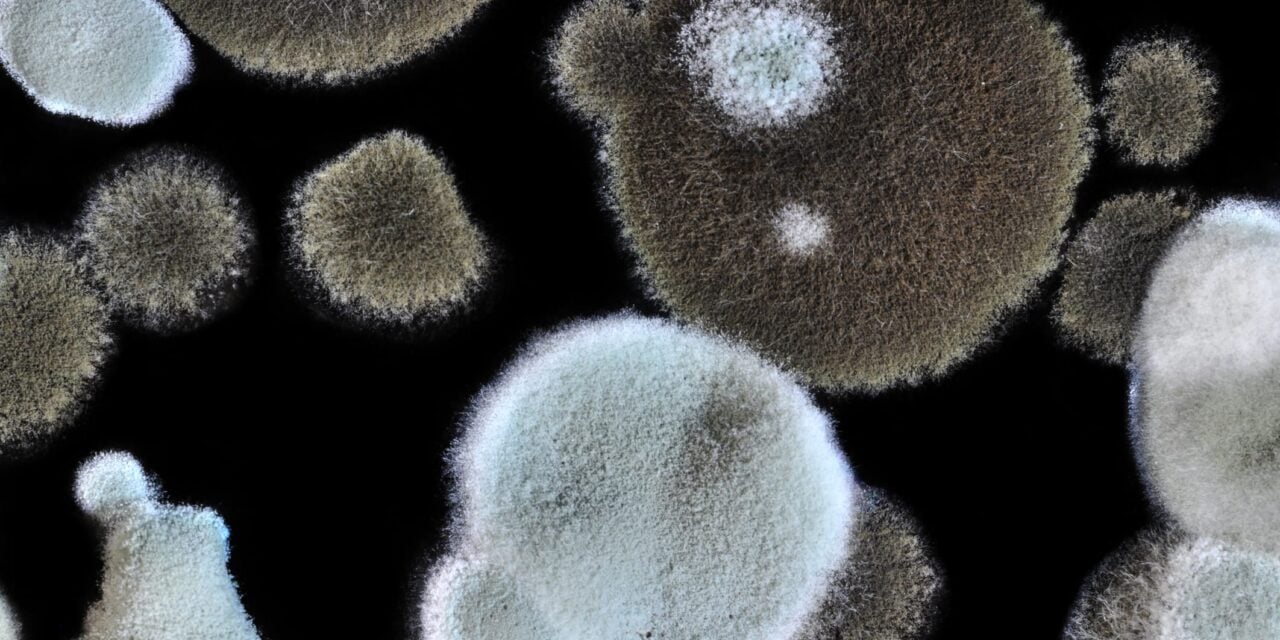

The plasma-based test detects cell-free DNA from 14 mold species and delivers results in less than 24 hours, according to the company.
Zepto Life Technology has launched the FungiFlex Mold Panel, a plasma-based molecular diagnostic test available through its CLIA-certified reference laboratory for detecting invasive fungal infections.
The test detects cell-free DNA from 14 clinically important mold species, including Aspergillus and Mucorales pathogens, from a single plasma sample. Results are delivered in less than 24 hours from sample receipt, according to the St. Paul, Minnesota-based company.
The FungiFlex Mold Panel represents the initial offering of Zepto’s liquid biopsy platform for infectious disease diagnostics and marks a step toward broader decentralized clinical use.
Invasive mold infections primarily affect immunocompromised patients and are among the most difficult infectious diseases to diagnose. These organisms are slow-growing and often require days to weeks to culture, while diagnosis frequently relies on invasive procedures such as biopsies or bronchoalveolar lavage. As a result, diagnosis is often delayed, contributing to high mortality rates.
“Delayed diagnosis remains one of the biggest challenges in managing invasive fungal infections,” says Hannah Zhang, CEO of Zepto Life, in a release. “By launching FungiFlex as a reference laboratory test, we are making this targeted approach available today, while advancing a platform designed for rapid deployment closer to patient care.”
Target Patient Population
The FungiFlex Mold Panel is intended for patients with symptoms of, or medical conditions predisposing them to, invasive fungal disease. This includes individuals undergoing transplantation or receiving immunosuppressive therapies.
The blood-based molecular approach enables earlier clinical insight without invasive sampling procedures. Samples are processed at Zepto Life Technology’s CLIA-certified laboratory in St. Paul, Minnesota.
The test detects small fragments of fungal DNA circulating in the bloodstream from the plasma sample. While initially offered as a reference laboratory test, the company says the platform is designed for eventual deployment closer to patient care settings.
ID 29008197 © Jan Havlicek | Dreamstime.com